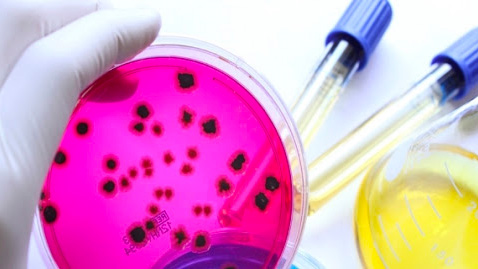

Microbiologia
Microbiologia
La Microbiologia dal greco micros (piccolo) e bios (vita) è una branca della biologia che studia la struttura e le funzioni dei microrganismi cioè di tutti quegli organismi viventi non visibili a occhio nudo, come: batteri, funghi, protozooi e anche virus.